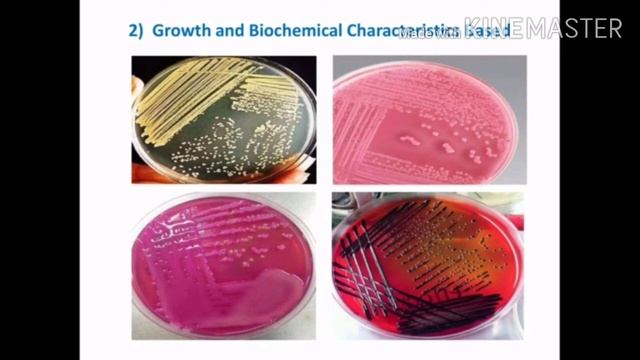
Identification of Microorganism || Dr. Sanjay Kumar, PhD смотреть онлайн

Автор: PHP Путешествие в мир разработки Страница 3

Photo taken on Congress Floor reveals Extraterrestrials watching session

Docker Registry - Nexus Sonatype OSS

Open webinar: Introduction to Docker for Hydroinformatics - Feb 9, 2021

TwinCAT 3 - Display Mode

Установка и эксплуатация замка зажигания ВАЗ 2108-2115 с выкидным ключом Ауди | MotoRRing.ru

Server Sent Events Demo

Realtime Sudoku Puzzle Solving Using OpenCV and DL4J - Part 2

Se prémunir des failles CSRF - Sécurité web

Moodle 4.0 Tutorial Videos-How to Locate Course Admin Settings

Seminar SPM, MAHIR TUTOR 23 Januari (Bahasa Inggeris, Bahasa Melayu)

Selenium 4 - Relative Locators
![[93599Productions] Sonic Classic Heroes - [2] Zone 3, Act 2 смотреть онлайн](https://pic.rutubelist.ru/video/4a/25/4a25623458e54112939ae2b45b565f31.jpg?size=m)
[93599Productions] Sonic Classic Heroes - [2] Zone 3, Act 2

Successful Artificial Intelligent trading software user

Ms Excel - Data Sorting Made Easy!

My 1973 Toyota Land Cruiser FJ40 - TulsaTurbo

Мастерская по ремонту электротранспорта "Лига Мастеров"

КУПИЛ АДМИНКУ НА ЧУЖОМ СЕРВЕРЕ ДЛЯ ТРОЛЛИНГА ИГРОКОВ НО МЕНЯ ЗАБАНИЛ АДМИН // ГРИФФЕРЫ В КСГО

One Week Virtual Workshop on Learning Practical Research Skills and Techniques

Templates Start Admin

How To Get Up To 3 Million Gold/Elixir An Hour in Clash of Clans! (Best Farming Strategy)
Identification of Microorganism || Dr. Sanjay Kumar, PhD

#3 CS:GO затащил с 5 хп

Linux Course in Telugu | Linux Tutorials in Telugu

Семена на 2023г. Часть 2!
За каждым успешным каналом стоит личность, идея и сотни часов кропотливого труда. Если вы здесь, значит, автор «PHP Путешествие в мир разработки» уже сумел зацепить ваше внимание своим уникальным стилем или подачей. А мы на RUVIDEO позаботились о том, чтобы вы могли изучить весь архив его работ в максимально комфортных условиях — без лишней суеты и преград.
Почему за работами канала «PHP Путешествие в мир разработки» так интересно наблюдать? Всё просто: это честный контент, который находит отклик в сердцах зрителей. На нашем ресурсе вы можете смотреть онлайн все видео любимого автора бесплатно и в хорошем качестве. Нам важно, чтобы вы видели каждую деталь и слышали каждый нюанс, поэтому мы используем только стабильные плееры из открытых источников Rutube.
Следите за новинками канала, пересматривайте старые шедевры и открывайте для себя новые грани творчества «PHP Путешествие в мир разработки». Мы постоянно обновляем ленту, чтобы у вас под рукой всегда были самые свежие выпуски. Никаких сложных регистраций — только вы и творчество, которое вдохновляет. Приятного вам путешествия по миру авторского контента на RUVIDEO!
Видео взято из открытых источников Rutube. Если вы правообладатель, обратитесь к первоисточнику.